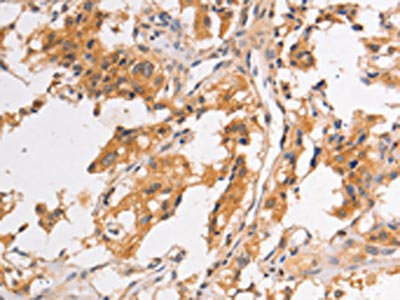

PIP5K1A Antibody
-
中文名稱:PIP5K1A兔多克隆抗體
-
貨號:CSB-PA094535
-
規格:¥1100
-
圖片:
-
The image on the left is immunohistochemistry of paraffin-embedded Human thyroid cancer tissue using CSB-PA094535(PIP5K1A Antibody) at dilution 1/30, on the right is treated with fusion protein. (Original magnification: ×200)
-
The image on the left is immunohistochemistry of paraffin-embedded Human brain tissue using CSB-PA094535(PIP5K1A Antibody) at dilution 1/30, on the right is treated with fusion protein. (Original magnification: ×200)
-
Gel: 6%SDS-PAGE, Lysate: 40 μg, Lane 1-2: PC3 cells, 293T cells, Primary antibody: CSB-PA094535(PIP5K1A Antibody) at dilution 1/300, Secondary antibody: Goat anti rabbit IgG at 1/8000 dilution, Exposure time: 40 seconds
-
-
其他:
產品詳情
-
Uniprot No.:
-
基因名:
-
別名:68 kDa type I phosphatidylinositol-4-phosphate 5-kinase alpha antibody; Phosphatidylinositol 4 phosphate 5 kinase type I alpha antibody; Phosphatidylinositol-4-phosphate 5-kinase type I alpha antibody; Phosphatidylinositol-4-phosphate 5-kinase type-1 alpha antibody; PI4P5K Ia antibody; PI51A_HUMAN antibody; PIP5K A antibody; PIP5K1-alpha antibody; Pip5k1a antibody; PIP5KIalpha antibody; PtdIns(4)P-5-kinase 1 alpha antibody
-
宿主:Rabbit
-
反應種屬:Human
-
免疫原:Fusion protein of Human PIP5K1A
-
免疫原種屬:Homo sapiens (Human)
-
標記方式:Non-conjugated
-
抗體亞型:IgG
-
純化方式:Antigen affinity purification
-
濃度:It differs from different batches. Please contact us to confirm it.
-
保存緩沖液:-20°C, pH7.4 PBS, 0.05% NaN3, 40% Glycerol
-
產品提供形式:Liquid
-
應用范圍:ELISA,WB,IHC
-
推薦稀釋比:
Application Recommended Dilution ELISA 1:2000-1:5000 WB 1:200-1:1000 IHC 1:25-1:100 -
Protocols:
-
儲存條件:Upon receipt, store at -20°C or -80°C. Avoid repeated freeze.
-
貨期:Basically, we can dispatch the products out in 1-3 working days after receiving your orders. Delivery time maybe differs from different purchasing way or location, please kindly consult your local distributors for specific delivery time.
-
用途:For Research Use Only. Not for use in diagnostic or therapeutic procedures.
相關產品
靶點詳情
-
功能:Catalyzes the phosphorylation of phosphatidylinositol 4-phosphate (PtdIns(4)P/PI4P) to form phosphatidylinositol 4,5-bisphosphate (PtdIns(4,5)P2/PIP2), a lipid second messenger that regulates several cellular processes such as signal transduction, vesicle trafficking, actin cytoskeleton dynamics, cell adhesion, and cell motility. PtdIns(4,5)P2 can directly act as a second messenger or can be utilized as a precursor to generate other second messengers: inositol 1,4,5-trisphosphate (IP3), diacylglycerol (DAG) or phosphatidylinositol-3,4,5-trisphosphate (PtdIns(3,4,5)P3/PIP3). PIP5K1A-mediated phosphorylation of PtdIns(4)P is the predominant pathway for PtdIns(4,5)P2 synthesis. Can also use phosphatidylinositol (PtdIns) as substrate in vitro. Together with PIP5K1C, is required for phagocytosis, both enzymes regulating different types of actin remodeling at sequential steps. Promotes particle ingestion by activating the WAS GTPase-binding protein that induces Arp2/3 dependent actin polymerization at the nascent phagocytic cup. Together with PIP5K1B, is required, after stimulation by G-protein coupled receptors, for the synthesis of IP3 that will induce stable platelet adhesion. Recruited to the plasma membrane by the E-cadherin/beta-catenin complex where it provides the substrate PtdIns(4,5)P2 for the production of PtdIns(3,4,5)P3, IP3 and DAG, that will mobilize internal calcium and drive keratinocyte differentiation. Positively regulates insulin-induced translocation of SLC2A4 to the cell membrane in adipocytes. Together with PIP5K1C has a role during embryogenesis. Independently of its catalytic activity, is required for membrane ruffling formation, actin organization and focal adhesion formation during directional cell migration by controlling integrin-induced translocation of the small GTPase RAC1 to the plasma membrane. Also functions in the nucleus where it acts as an activator of TUT1 adenylyltransferase activity in nuclear speckles, thereby regulating mRNA polyadenylation of a select set of mRNAs.
-
基因功能參考文獻:
- KRAS-specific interactor that mediates oncogenic KRAS signaling and proliferation PMID: 30194290
- Blockade of IQGAP1 interaction with PIPKIalpha or PI(3)K inhibited PtdIns(3,4,5)P3 generation and signalling, and selectively diminished cancer cell survival. PMID: 27870828
- These results indicate that PP1 is recruited to the extracellular calcium-dependent E-cadherin-catenin-PIP5K1a complex in the plasma membrane to activate PIP5K1a, which is required for PLC-g1 activation leading to keratinocyte differentiation. PMID: 27340655
- PIP5K1A is modified by polySUMO-2 only during apoptosis. PMID: 23994136
- CD28 regulates phosphatidylinositol 4,5-biphosphate turnover by recruiting and activating phosphatidylinositol 4-phosphate 5-kinases alpha in human primary CD4(+) T lymphocytes. PMID: 23589613
- Results define the role of PIPKI-alpha in cell migration and describes a new mechanism for the spatial regulation of Rac1 activity that is critical for cell migration. PMID: 20660631
- Localized production of Phosphatidylinositol 4,5-bisphosphate by PIP5K1A is required for invadopodia formation by breast cancer cells. PMID: 20426790
- Membrane ruffling requires coordination between this enzyme and Rac signaling. PMID: 12682053
- in addition to its effects upon Rac activity, Ajuba can also influence cell migration through regulation of PI(4,5)P2 synthesis through direct activation of PIPKIalpha enzyme activity PMID: 15870270
- identified apoptotic stimuli that initiate a signaling pathway during cell death that leads to caspase-independent downregulation of PIP5Kalpha. PMID: 16979564
- Type I phosphatidylinositol-4-phosphate-5-kinase (PI5KI) alpha and gamma isoforms were identified as the enzymes responsible for PIP2 synthesis in natural killer cells. PMID: 18073347
- beta-arrestins direct the localization of PIP5K Ialpha and PIP(2) production to agonist-activated 7TMRs, thereby regulating receptor internalization PMID: 18534983
- PI4P5-K Ialpha-mediated PIP(2) production is crucial for HIV-1 entry and the early steps of infection in permissive lymphocytes. PMID: 18981107
- Extracellular calcium (Cao) stimulated PIP5K1alpha recruitment to the E-cadherin-catenin complex in the plasma membrane. PMID: 19158393
- The data suggest that activation of FcgammaRIIA leads to membrane rafts coalescing into signaling platforms containing PIP5-kinase Ialpha and PI(4,5)P(2). PMID: 19331818
顯示更多
收起更多
-
亞細胞定位:Cell membrane. Cytoplasm. Nucleus. Nucleus speckle. Cell projection, ruffle. Cell projection, lamellipodium.
-
組織特異性:Highly expressed in heart, placenta, skeletal muscle, kidney and pancreas. Detected at lower levels in brain, lung and liver.
-
數據庫鏈接:
Most popular with customers
-
-
YWHAB Recombinant Monoclonal Antibody
Applications: ELISA, WB, IHC, IF, FC
Species Reactivity: Human, Mouse, Rat
-
Phospho-YAP1 (S127) Recombinant Monoclonal Antibody
Applications: ELISA, WB, IHC
Species Reactivity: Human
-
-
-
-
-